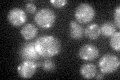
YOL137W
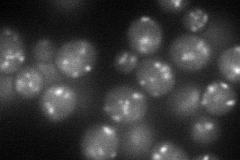
YOL137W
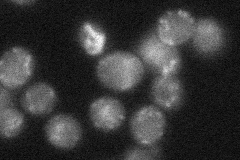
YOL137W
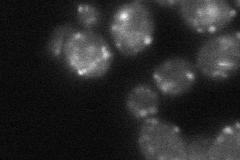
YOL137W
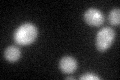
YOL137W
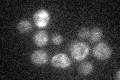
YOL137W

View description
Protein of unknown function containing 8 putative transmembrane seqments; ORF exhibits genomic organization compatible with a translational readthrough-dependent mode of expression
Localization:
Intensity:
Fold change:
Significance:
-
C’ GFP library in SD
punctate20.18 -
N' NOP1pr-GFP in SD
punctate67.4201 -
N' TEF2pr-mCherry in SD

punctate81.9742 -
N' NATIVEpr-GFP in SD
punctate24.8939 -
N' TEF2pr-VC and Cyto-VN in SD
ER44.478 -
C’ GFP library in SD+DTT
punctate18.110.89No -
C’ GFP library in SD+H2O2

punctate16.150.8No -
C’ GFP library in Starvation Media
punctate20.751.02No -
C’ GFP library on the background of Pup2-DaMP

punctate -
C’ GFP library on the background of CCT mutant

punctate17.14220.848891No
